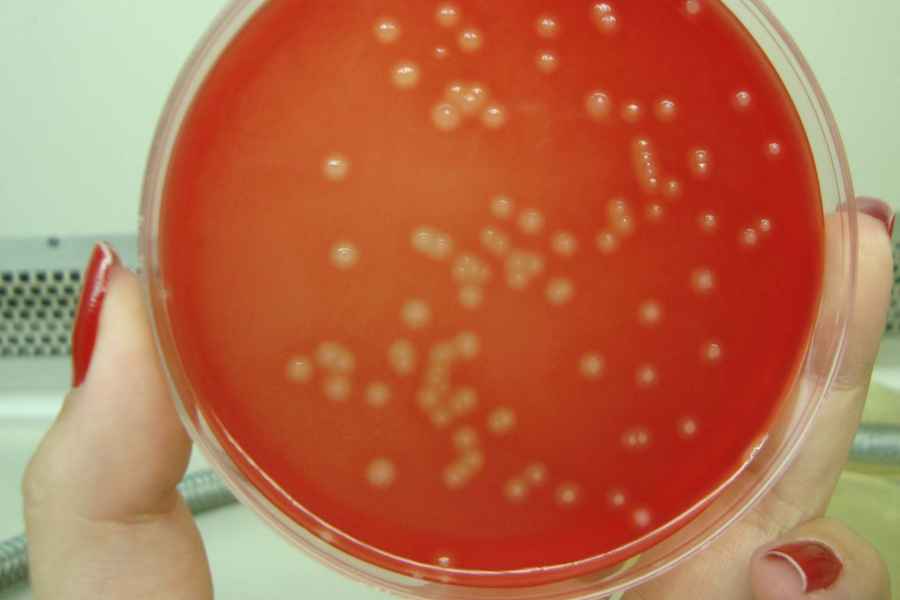
Vacuna que trata y previene el shock t&oacute;xico mortal causado por estreptococos

Mostrando artículos por etiqueta: vacuna
Brasil prueba posible vacuna para Covid-19
La posible vacuna para el nuevo coronavirus desarrollada por la Universidad de Oxford, en el Reino Unido, se comenzará a probar en pacientes en Brasil este mes. Así lo confirmó el Ministerio de Salud del país sudamericano este miércoles, de acuerdo con O Globo.
Brasil, en efecto, apoyará la iniciativa con 2.000 voluntarios que no entraron en contacto con la enfermedad, tanto en Río como en San Pablo, las dos ciudades más afectadas por la pandemia en el país sudamericano. Así, será parte del plan global de desarrollo de vacunas y será el primer país en llevar a cabo las pruebas de Oxford después del Reino Unido.
El procedimiento fue aprobado por la Agencia Nacional de Vigilancia Sanitaria (Anvisa) y, en San Pablo, los estudios serán dirigidos por el Centro de Referencia para Inmunobiológicos Especiales (Crie) de la Universidad Federal del estado (Unifesp).
La infraestructura médica y los equipos serán financiados por la Fundación Lemann, y los primeros mil voluntarios, de San Pablo, serán reclutados por Unifesp; mientras que las otras 1.000 personas serán parte de la prueba en Río de Janeiro.
La vacuna producida por la universidad británica fue incluida en un estudio realizado por el banco de inversión Morgan Stanley, que mapeó 110 búsquedas de una fórmula inmunizante, y se considera que es una de las seis candidatas más prometedoras para curar la enfermedad que afecta al planeta.
La idea es que el estudio aleatorizado evalue la seguridad y la eficacia del inmunizador. La agencia, por su parte, señaló que los ensayos clínicos en humanos realizados bajo el sello británico demostraron ser seguros.
Para Natália Pasternak, investigadora colaboradora del Laboratorio de Desarrollo de Vacunas del Instituto de Ciencias Biomédicas de la USP, citada por O Globo, la noticia llega en un buen momento no solo por el empeoramiento de la pandemia en Brasil, sino también porque contribuye a echar luz sobre la capacidad científica brasileña.
“Una de las principales ventajas para Brasil es el hecho de ser parte de un estudio internacional. Es una contribución importante en un momento en que el país tiene una mala imagen internacional, ya que la pandemia se está manejando extremadamente mal y esto pone a todo el mundo en peligro”, analizó la investigadora y también columnista del blog A Hora da Ciência.
Las pruebas de la vacuna británica en Brasil van a contramano de la estrategia del gobierno federal, que está tratando de impulsar el uso profiláctico de la hidroxicloroquina.
“Lo que funciona es la vacuna. Eso es en lo que tenemos que invertir. No en una droga que nunca ha sido científicamente efectiva contra Covid-19”, añadió Pasternak respecto de la estrategia del gobierno de Jair Bolsonaro, que siempre ha desestimado las recomendaciones de los profesionales sanitarios.
Otra ventaja es que, si se demuestra su eficacia, el acuerdo con Oxford podría facilitar la producción de la fórmula en el país: “Tener el acuerdo directamente con el Instituto Jenner, en Oxford, hace que sea mucho más fácil cuando tenemos que implementar tecnología de producción aquí. En algún momento, si resulta efectivo, todo el mundo querrá producirlo y Brasil tendrá la ventaja de tener este acuerdo firmado”, dijo la especialista.
No obstante, como dato negativo Pasternak admitió que si Oxford ha elegido a Brasil como el país para hacer las primeras pruebas, esto se debe a las dificultades que tiene el país en la gestión de la pandemia. Con 555.383 casos confirmados de la enfermedad, es el segundo país más afectado en el mundo, solo por detrás de los Estados Unidos. Registra al miércoles casi 32.000 muertes, la cuarta cifra más alta a nivel global.
El estudio se llevará adelante con un método sencillo: se dividirán a los voluntarios en dos; uno de ellos recibirá la vacuna y el otro, un placebo.
La vacuna Oxford fue creada a partir de un adenovirus de chimpancé. La fórmula se basa en el llamado vector viral, es decir, un virus que no es Sars-CoV-2 (que causa Covid-19) en el que se clona la secuencia genética del nuevo coronavirus, para estimular las respuestas inmunes. Las primeras fases de trabajo en el Reino Unido fueron prometedoras.
Vacuna presentó resultados prometedores
Moderna Inc. informó que su vacuna experimental contra el COVID-19 mostró resultados prometedores en sus estudios iniciales y espera pasar en julio a la siguiente fase de la investigación con ensayos clínicos. La vacuna, llamada mRNA-1273, además resultó ser segura en general y fue bien tolerada en los estudios preliminares, dijo la farmacéutica.
Los niveles de los anticuerpos presentados en los voluntarios fueron similares a los de las muestras de sangre de personas que se recuperaron de COVID-19, mostraron los primeros resultados del estudio realizado por los Institutos Nacionales de Salud.
Los participantes recibieron tres dosis diferentes de la vacuna y Moderna dijo que vio un aumento dependiente de la dosis en la inmunogenicidad, la capacidad de provocar una respuesta inmune en el cuerpo.
Otro de los puntos muy destacado es que también se descubrió que la vacuna mRNA-1273, en general es segura y bien tolerada en el estudio inicial, dijo el laboratorio. Moderna Inc. lidera los esfuerzos globales en el desarrollo de una vacuna para el nuevo coronavirus y la semana pasada ganó la etiqueta de “vía rápida” de la agencia de salud de los Estados Unidos para acelerar la revisión regulatoria. Está buscando comenzar los ensayos en etapa tardía en julio.
Como consecuencia del anuncio de la farmacéutica, las acciones futuras de Nueva York presentaban fuertes subas. Lo mismo ocurría con los mercados de valores de Europa.
Hace 11 días la Administración de Drogas y Alimentos de los Estados Unidos (FDA, por sus siglas en inglés) había aprobado que la vacuna de Moderna para el coronavirus proceda a la fase dos de su estudio. La información había sido dada a conocer la propia compañía este jueves en un comunicado de prensa, en el que indicó que se estima que la nueva fase comience en breve.
“La Administración de Drogas y Alimentos de los EEUU (FDA) completó su revisión de la solicitud de Investigación de Nuevos Medicamentos (IND) de la compañía para su nuevo candidato a la vacuna contra el coronavirus (SARS-CoV-2 o COVID-19) (ARNm-1273), que le permite pasar a la Fase 2 de estudio. Se espera que comience en breve. El protocolo de finalización para el estudio de Fase 3 del ARNm-1273, se espera que comience a principios del verano de 2020”, indica el comunicado de Moderna.
La vacuna mRNA-1273 fue la primera norteamericana en comenzar las pruebas clínicas en Estados Unidos. El ensayo ayudará a los investigadores a evaluar si la vacuna es segura, quién produce la respuesta inmune más fuerte que podría defenderse de la cepa letal y cuál debería ser la dosis eficiente para tratar el mal.
Esta vacuna -como todas las que están en proceso- utiliza una tecnología basada en genes conocida como ARN mensajero. El ARN mensajero, o ARNm, lleva instrucciones del ADN a las células del cuerpo para producir ciertas proteínas. Una vacuna de ARNm nunca ha sido aprobada para prevenir enfermedades infecciosas.
Pfizer y BioNTech: primer ensayo de vacuna
Pfizer y BioNTech anunciaron que el Instituto PaulEhrlich, como autoridad regulatoria en Alemania, aprobó los estudios clínicos fase 1/2 para el programa de BNT162, que realizan en conjunto Pfizer y BioNTech para desarrollar la vacuna que prevenga la infección del COVID-19.
Este es el primer ensayo clínico de la vacuna candidata contra el COVID19 que se iniciará en Alemania y es parte de un programa de desarrollo global. Pfizer y BioNTech también realizarán ensayos clínicos en Estados Unidos tan pronto se obtenga la autorización regulatoria correspondiente, la cual se espera en los próximos días.
Las cuatro vacunas candidatas son las primeras del proyecto "Lightspeed" de BioNTech centrado en COVID19. Cada una representa distintos formatos de ARNm y antígenos objetivo. Dos de ellas incluyen nucleótidos modificados de ARNm (modARN), una incluye uridina de ARNm (uARN) y la cuarta, utiliza ARNm auto ampliable (saARN).
Cada formato de ARNm se combina con una formulación de nanopartículas lipídicas (LNP, por sus siglas en inglés). La secuencia completa de proteína espiga se incluye en dos de las vacunas candidatas y un pequeño y optimizado receptor de unión de la proteína espiga (RBD, por sus siglas en inglés) se incluye en las otras dos. Las vacunas basadas en el dominio de unión al receptor contienen la parte de la espiga que se considera más importante para provocar anticuerpos que pueden inactivar el virus.
La parte del estudio fase 1/2 que involucra escalación de dosis incluirá aproximadamente a 200 personas saludables de entre 18 y 55años y se les administrará una dosis entre 1 y 100 µg para determinar la dosis óptima para los siguientes estudios, así como para evaluar la seguridad e inmunogenicidad de la vacuna. Este estudio también evaluará los efectos de repetidas inmunizaciones para tres de las cuatro vacunas que utilizan ácido ribonucleico uridina (uARN) o modificado (modARN). Los sujetos con mayor riesgo de una infección de COVID- 19 serán incluidos en la segunda parte del estudio.
"Estamos orgullosos de haber completado los estudios preclínicos en Alemania y haber recibido esta importante aprobación regulatoria para comenzar este primer ensayo en humanos. La velocidad con la que pudimos movernos desde el comienzo del programa, hasta las autorizaciones regulatorias para comenzar este ensayo, habla del alto nivel de compromiso de cada uno de los involucrados", dijo Ugur Sahin, CEO y cofundador de BioNTech.
"La colaboración de Pfizer y BioNTech ha movilizado nuestros recursos a una velocidad extraordinaria para enfrentar este reto mundial", dijo Albert Bourla, Presidente y CEO de Pfizer. "Ahora que el trabajo puede comenzar en Alemania, esperamos y nos preparamos activamente para el arranque potencial de este robusto y único estudio clínico en los Estados Unidos en el futuro cercano".
Durante la etapa de desarrollo clínico, BioNTech proveerá a sus socios abastecimiento clínico de la vacuna desde sus plantas localizadas en Europa. BioNTech también colabora con Fosun Pharma para desarrollar BNT162 en China, en donde la compañía espera realizar más ensayos.
Sarampión, nuevo brote
En plena cuarentena por el COVID-19, los argentinos –y el mundo- estamos viviendo una pandemia que, como no cuenta con una vacuna, afecta a una gran cantidad de personas y genera consecuencias devastadoras tanto a nivel sanitario como económico. En este contexto, la Sociedad Argentina de Pediatría (SAP) llamó a establecer un paralelismo con el sarampión: una condición para la que sí hay vacuna, y que si bien se suponía que estaba bastante controlada a nivel mundial, en nuestro medio está atravesando un nuevo brote –el más extenso desde la eliminación de la circulación endémica en buena medida por la no vacunación de los menores.
El sarampión es una enfermedad viral altamente transmisible de persona a persona a través de secreciones nasales o de la boca de personas infectadas. Puede producir una enfermedad potencialmente fatal, sobre todo en los niños más vulnerables y si bien no tiene un tratamiento específico, sí se dispone de una vacuna segura y eficaz que está incluida en nuestro Calendario Nacional de Inmunizaciones, gratuito y obligatorio.
"Contar con vacunas contra una enfermedad es un avance sanitario muy grande. Con el COVID-19, lamentablemente, estamos viviendo lo que sucede ante una enfermedad infecciosa para la que no desarrollamos aún una vacuna eficaz. Por este motivo, para aquellas enfermedades para las que sí disponemos de vacunas, no cumplir con el esquema de vacunación es realmente peligroso y lleva a las consecuencias que estamos viviendo: el brote de sarampión que apareció en Argentina después de haber logrado ser un país libre de la circulación de este virus", detalló la Dra. Elizabeth Patricia Bogdanowicz, Médica Infectóloga Pediatra, miembro del Comité de Infectología Pediátrica de la SAP.
Dicho brote ya lleva 160 infectados. De ellos, 107 se registraron en 2019 (de los cuales, 7 fueron importados o relacionados a la importación), y 53 en 2020 (reportes al 5/4/20 - 9 casos importados y 44 de origen desconocido).
La inmunización contra el sarampión está incluida en la vacuna denominada 'triple viral' -que inmuniza también contra paperas y rubeola- y que se administra de manera gratuita y obligatoria.
Nuestro calendario de vacunación obligatorio incluye dos dosis que se aplican en cualquier hospital o centro asistencial; la primera a los 12 meses de vida y la segunda al momento del ingreso escolar, entre los 5 y los 6 años. Como medidas de prevención también se recomienda evitar el contacto con personas que puedan estar enfermas, utilizar tapabocas y lavarse las manos con frecuencia.
Dada la situación actual, se recomienda una "dosis cero" a los bebes de entre 6 y 12 meses que viven en áreas de circulación viral reconocida (esta dosis no se contabiliza y se comienza el esquema oficial al cumplir 1 año de edad); dosis que no hace falta en aquellos que viven en provincias donde no hay circulación viral. Luego, todos los mayores a 5 años deben acreditar al menos las dos dosis contempladas en el calendario. Mientras que los mayores que nacieron antes de 1965 son considerados inmunes y no deben vacunarse", explicó la Dra. Gabriela Nidia Ensinck, médica infectóloga pediatra, Secretaria del Comité de Infectología de la SAP.
Por otra parte, desde la SAP recordaron que la administración de la vacuna está contraindicada en aquellas personas inmunosuprimidas o embarazadas y que se debe evitar el embarazo en el mes siguiente a haber recibido una dosis.
"Una vez que se normalice la situación del COVID-19 y sea seguro nuevamente trasladarse, si en la familia hay menores de 6 meses, se debe evitar viajar a regiones donde se conoce que hay circulación del virus. En el caso de las embarazadas que tengan que viajar, se recomienda que acrediten al menos dos dosis de la vacuna aplicada después del año de vida o confirmar a través de un estudio de laboratorio la presencia de anticuerpos contra el sarampión. Se desaconseja viajar a las embarazadas sin antecedentes comprobables de vacunación o sin anticuerpos contra el sarampión", subrayó la Dra. Ángela Gentile, infectóloga del Comité de Infectología de la SAP y Presidenta de la Comisión Nacional para la Eliminación del Sarampión y la Rubeola.
"El desafío en este momento es la vacunación de los niños en el marco de las medidas que se están tomando para la prevención de la enfermedad por COVID-19, es por ello que se decidió que junto con la vacunación antigripal en los menores de dos años se ofrezca también la vacuna triple viral según las indicaciones actuales", agregó Dra. Gentile, quien también integra el Comité de Expertos Covid-19 de la Ciudad de Buenos Aires y de la Nación.
Desde la SAP recomiendan optimizar la oportunidad y calidad en el control de todo caso sospechoso, que son aquellos que presenten fiebre y exantema (erupción en la piel), independientemente de su edad y de sus antecedentes de vacunación. También destacaron la importancia de aprovechar todo contacto de la población con el sistema de salud para controlar carnets/libretas de vacunación y completar esquemas en los casos necesarios, con el fin de alcanzar coberturas satisfactorias y disminuir el número de personas susceptibles, previniendo así la propagación de la enfermedad.
Algunos de los signos y síntomas que pueden indicar la presencia de sarampión son fiebre alta, secreción nasal, tos, conjuntivitis, manchas blancas en la boca y cara interna de la mejilla y manchas rojas en la piel. Su aparición amerita la consulta inmediata (inicialmente telefónica, dadas las circunstancias actuales) con el pediatra de confianza.
Ante un caso confirmado, se debe disponer el aislamiento del paciente hasta los 7 días siguientes del inicio de los síntomas para evitar contagios. Evitar la circulación en transportes públicos y dentro de las instituciones. Asimismo, quienes hayan estado en contacto con él y tengan entre 6 y 12 meses deberán recibir una dosis de la vacuna triple viral. Quienes tengan entre 13 meses y 54 años deberán asegurarse de contar con dos dosis.
Pfizer y BioNTech desarrollarán potencial vacuna contra el COVID-19
Pfizer Inc. y BioNTech SE anunciaron hoy que las compañías han acordado una carta de intención en relación con el desarrollo conjunto y la distribución (excluida China) de una posible vacuna contra el coronavirus, basada en ARNm, con el objetivo de prevenir la infección por COVID-19. Las compañías han ejecutado un Acuerdo de Transferencia de Materiales y Colaboración para que las partes comiencen a trabajar juntas de inmediato.
La alianza apunta a acelerar el desarrollo del potencial programa de vacuna del ARNm COVID-19 de BioNTech, el primero en su clase, BNT162, que se espera que sea sometido a pruebas clínicas a finales de abril de 2020.
El rápido avance de esta alianza se basa en la labor conjunta de investigación y desarrollo que Pfizer y BioNTech constituyeron en 2018 para desarrollar vacunas basadas en el ARNm para la prevención de la influenza.
"Estamos orgullosos de que nuestra relación continua y exitosa con BioNTech le brinde a nuestras compañías la capacidad de movilizar nuestros recursos colectivos con una velocidad extraordinaria frente a este desafío mundial", expresó Mikael Dolsten, Director Científico y Presidente Global de Investigación, Desarrollo y Asuntos Médicos de Pfizer.
"Creemos que al combinar las capacidades de desarrollo, regulatorias y comerciales de Pfizer con la tecnología y experiencia en vacunas ARNm de BioNTech como uno de los líderes de la industria, estamos reforzando nuestro compromiso de hacer todo lo posible para combatir esta creciente pandemia, lo más rápido posible", agregó.
“Esta es una pandemia global que requiere una iniciativa global. Al unir fuerzas con nuestro socio Pfizer, creemos que podemos acelerar nuestros esfuerzos para llevar una vacuna COVID-19 a las personas de todo el mundo que la necesitan", indicó Ugur Sahin, cofundador y CEO de BioNTech.
Las compañías esperan utilizar múltiples sitios de investigación y desarrollo de ambas compañías, incluso en Estados Unidos y Alemania, para instalar las actividades identificadas por el Acuerdo de Colaboración.
Las compañías comenzarán a colaborar de inmediato. Finalizarán los detalles del Acuerdo con respecto a los términos financieros y todas las actividades relacionadas con el desarrollo, la fabricación y la potencial comercialización durante las próximas semanas.
El 13 de marzo de 2020, Pfizer emitió un plan de cinco puntos en el cual solicitaba a la industria biofarmacéutica que se uniera a la compañía para comprometerse a una colaboración sin precedentes para combatir el COVID-19.
La vacuna contra el colesterol llegará a la sanidad pública inglesa este año
El Servicio Nacional de Salud (NHS) en Inglaterra pondrá este año a disposición de los pacientes una vacuna que reduce el colesterol malo, como parte de un ensayo clínico a gran escala, tras llegar a un acuerdo con el laboratorio fabricante Novartis, informan medios británicos.
Millones de personas toman diariamente píldoras de estatinas para reducir el colesterol, pero este nuevo medicamento llamado inclisiran promete mantener el colesterol a raya con solo dos pinchazos al año.
El secretario de Salud, Matt Hancock, destacó que la iniciativa podría salvar 30.000 vidas durante la próxima década.
Cuando los niveles de colesterol en sangre se elevan por encima de los 240 el riesgo de sufrir un infarto de miocardio se duplica comparado con aquellos que lo mantienen en 200. Cuando las células son incapaces de absorber todo el colesterol que circula por la sangre, el sobrante se deposita en la pared de la arteria y contribuye a su progresivo estrechamiento originando la arterosclerosis.
El nuevo medicamento funciona «silenciando» el gen PCSK9 para que el hígado absorba más colesterol «malo» de la sangre y lo descomponga.
Los ensayos de inclisiran presentados en la Sociedad Europea de Cardiología el año pasado mostraron que podría reducir los niveles de colesterol malo a la mitad en semanas. El profesor Kausik Ray, que dirigió esos ensayos, del Imperial College London, aseguró que esto le da un potencial «enorme», informa la BBC. Y el Departamento de Salud y Atención Social dice que evitaría 55.000 ataques cardíacos y accidentes cerebrovasculares cada año por cada 300.000 pacientes tratados.
El NHS invitará a participar en este gran ensayo a los pacientes que no hayan sufrido un ataque cardíaco o un derrame cerebral, pero que corran un alto riesgo de sufrir uno. Las autoridades sanitarias calculan que unas 40.000 personas podrían cumplir este requisito.
Fuente: ABC España ( España )
El sarampión elimina la memoria inmune del organismo hasta tres años
Durante la última década se ha acumulado evidencia de que la vacuna contra el sarampión protege de dos maneras ya que, no solo previene la enfermedad aguda que con frecuencia envía a los niños al hospital, sino que también parece proteger contra otras infecciones a largo plazo. Los investigadores han descubierto ahora el mecanismo y el alcance de la amnesia inmune inducida por el sarampión a raíz de la infección.
Algunos investigadores han sugerido que la vacuna da un impulso general al sistema inmune. Otros plantearon la hipótesis de que los efectos protectores extendidos de la vacuna provienen de la prevención de la infección por sarampión.
Según esta teoría, el virus puede dañar la memoria inmune del cuerpo, causando la llamada amnesia inmune. Al proteger contra la infección de sarampión, la vacuna evita que el cuerpo pierda u “olvide” su memoria inmune y preserva su resistencia a otras infecciones.
Investigaciones anteriores insinuaron los efectos de la amnesia inmune, mostrando que la supresión inmune después de la infección por sarampión podría durar hasta dos o tres años. Sin embargo, muchos científicos aún debaten qué hipótesis es correcta ya que, si la amnesia inmune es real, cómo sucede exactamente y cómo es de grave.
Ahora, un estudio de un equipo internacional de investigadores dirigido por investigadores de la Escuela de Medicina de Harvard, el Hospital Brigham and Women’s y la Escuela de Salud Pública de Harvard TH Chan, publicado en la revista ‘Science’, proporciona respuestas.
Los investigadores muestran que el virus del sarampión elimina del 11 al 73 por ciento de los diferentes anticuerpos que protegen contra las cepas virales y bacterianas a las que una persona era previamente inmune, desde la gripe hasta virus del herpes o bacterias que causan neumonía e infecciones de la piel.
Entonces, si una persona tenía 100 anticuerpos diferentes contra la varicela antes de contraer sarampión, podría salir de tener sarampión con solo 50, reduciendo a la mitad su protección contra la varicela. Esa protección podría disminuir aún más si algunos de los anticuerpos perdidos son defensas potentes conocidas como anticuerpos neutralizantes.
El estudio es el primero en medir el daño inmune causado por el virus y subraya el valor de prevenir la infección por sarampión mediante la vacunación
“La amenaza que representa el sarampión para las personas es mucho mayor de lo que imaginamos anteriormente –apunta el autor principal Stephen Elledge, profesor de Genética y Medicina Gregor Mendel en el Instituto Blavatnik de la Facultad de Medicina de Harvard y el Hospital Brigham and Women’s–. Ahora entendemos que el mecanismo es un peligro prolongado debido a la eliminación de la memoria inmune, lo que demuestra que la vacuna contra el sarampión es aún más beneficiosa de lo que sabíamos”.
El descubrimiento de que el sarampión agota los repertorios de anticuerpos de las personas, destruyendo parcialmente la memoria inmune a la mayoría de los patógenos encontrados anteriormente, respalda la hipótesis de la amnesia inmune.
“Esta es la mejor evidencia hasta ahora de que existe amnesia inmune e impacta nuestra memoria inmune de buena fe a largo plazo”, agrega Mina, quien descubrió por primera vez los efectos epidemiológicos del sarampión en la mortalidad infantil a largo plazo en un artículo de 2015.
El trabajo del equipo fue publicado simultáneamente con un artículo de un equipo separado en ‘Science Immunology’ que llegó a conclusiones complementarias al medir los cambios en las células B causados por el virus del sarampión. Un editorial acompañante en ‘Science Immunology’, escrito por Duane Wesemann, profesor asistente de medicina de la Facultad de Medicina de Harvard en el Hospital Brigham and Women’s, contextualiza ese estudio.
Elledge, Mina y sus colegas descubrieron que aquellos que sobreviven al sarampión recuperan gradualmente su inmunidad previa a otros virus y bacterias a medida que se vuelven a exponer a ellos. Pero debido a que este proceso puede llevar meses o años, las personas siguen siendo vulnerables mientras tanto a las complicaciones graves de esas infecciones.
A la luz de este hallazgo, los investigadores dicen que los médicos pueden considerar fortalecer la inmunidad de los pacientes que se recuperan de la infección por sarampión con una ronda de inyecciones de refuerzo de todas las vacunas de rutina anteriores, como la hepatitis y la poliomielitis.
“La revacunación después del sarampión podría ayudar a mitigar el sufrimiento a largo plazo que podría derivarse de la amnesia inmune y la mayor susceptibilidad a otras infecciones”
Según la Organización Mundial de la Salud, el sarampión, una de las enfermedades más contagiosas conocidas por la humanidad, mató a 2,6 millones de personas de media cada año antes de que se desarrollara una vacuna.
La vacunación generalizada ha reducido el número de muertes pero la falta de acceso a la vacuna y la negativa a vacunarse significa que el sarampión todavía infecta a más de 7 millones de personas y mata a más de 100.000 cada año en todo el mundo, informa la OMS, y los casos están en aumento, triplicándose a principios de 2019.
Investigaciones epidemiológicas previas sobre la amnesia inmune sugieren que las tasas de mortalidad atribuidas al sarampión podrían ser aún mayores, representando hasta el 50 por ciento de toda la mortalidad infantil, si los investigadores tuvieran en cuenta las muertes causadas por infecciones causadas por los efectos devastadores del sarampión en la inmunidad.
Este nuevo descubrimiento fue posible gracias a ‘VirScan’, una herramienta de Elledge y Tomasz Kula, estudiante de doctorado en Elledge Lab, desarrollado en 2015. Detecta anticuerpos antivirales y antibacterianos en la sangre que resultan de encuentros actuales o pasados con virus y bacterias, dando una imagen general del sistema inmune.
Los autores destacan que los efectos observados en el estudio actual ocurrieron en niños previamente sanos. Debido a que se sabe que el sarampión afecta mucho más a los niños desnutridos, el grado de amnesia inmune y sus efectos podrían ser aún más graves en poblaciones menos saludables.
“El niño promedio podría salir del sarampión con una ‘abolladura’ en su sistema inmunológico y su cuerpo podrá manejar eso –ejemplifica Elledge–. Pero los niños al límite, como aquellos con infección grave de sarampión o deficiencias inmunes o aquellos que están desnutridos, tendrán serios problemas”.
Los resultados se alinean con décadas de investigación. Asegurar la vacunación generalizada contra el sarampión no solo ayudaría a prevenir las 120.000 muertes que se atribuirán directamente al sarampión solo este año, sino que también podría evitar potencialmente cientos de miles de muertes adicionales atribuibles al daño duradero del sistema inmune, recuerdan los autores.
“Esto destaca la importancia de comprender y prevenir los efectos a largo plazo del sarampión, incluidos los efectos silenciosos que han pasado desapercibidos para los médicos y los padres –advierte Mina–. Si su hijo contrae el sarampión y luego contrae neumonía dos años después, no necesariamente los uniría, pero los síntomas del sarampión en sí pueden ser solo la punta del iceberg”.
Fuente: Europa Press / COFA
Avanza la investigación de una vacuna contra el virus respiratorio sincitial
Científicos de la Universidad Estatal de Ohio (Estados Unidos) avanzaron en la investigación de una vacuna contra el virus respiratorio sincitial (VRS). Sus hallazgos ofrecen una estrategia para encontrar una vacuna lo suficientemente débil como para no provocar la enfermedad, pero lo suficientemente fuerte para activar una respuesta inmune amplia, y asegurándose de que el cuerpo reconozca el RSV como un intruso en el futuro.
En su estudio, publicado este miércoles en la revista ‘Nature Communications’, los investigadores explican cómo tuvieron éxito en eliminar una modificación epigenética conocida como N6-metiladenosina en el ARN del VRS, una técnica que demostró que provoca una inmunidad robusta en ratas.
Utilizando una técnica llamada genética inversa, los investigadores generaron VRS defectuoso en la metilación de N6-metiladenosina, una de las modificaciones más comunes que las células hacen al ARN.
“El uso de este virus modificado en una vacuna puede mejorar la respuesta inmune innata de una persona, un desafío que ha impedido el desarrollo de esta inmunización en el pasado”.
Este descubrimiento también podría hacer que la producción de vacunas sea económicamente más factible porque no frena el crecimiento del VRS en el laboratorio, un paso crítico en la producción de vacunas. El VRS es común, se propaga fácilmente y generalmente causa síntomas leves parecidos al resfrío. Pero en casos severos, particularmente en bebés menores de un año y ancianos, puede ser mortal. En todo el mundo, más de 80.000 niños mueren por estas infecciones cada año.
Fuente: Europa Press / COFA
Llaman a aplicarse la vacuna del sarampión
A partir de los brotes de sarampión presentes en la región y el intercambio permanente turístico, comercial y laboral, la Secretaría de Gobierno de Salud llama a la población a acercarse a un centro de salud u hospital para recibir la vacuna en caso de no habérsela aplicado con anterioridad.
Tal como indica el Calendario Nacional de Vacunación, los niños de 12 meses a 5 años deben acreditar una dosis de vacuna triple viral (que protege contra el sarampión, la rubéola y las paperas) mientras que los mayores de 5 años tienen que contar con dos dosis de vacuna doble o triple viral. Las personas nacidas antes de 1965 no necesitan vacunarse porque se consideran protegidos por haber estado en contacto con el virus.
La circulación del virus del sarampión en la Región de las Américas continúa activa. Durante el año se notificaron más de 4.500 casos confirmados, los cuales se concentraron en su mayoría en Estados Unidos y Brasil. Además, cabe destacar que según el Boletín Epidemiológico del Ministerio de Salud de Brasil, en el período que abarca desde el 09 de junio al 31 de agosto fueron confirmados por laboratorio un total de 2.753 casos, de estos el 98.3% se concentran en dos municipios del estado de San Pablo, en especial en la región metropolitana.
Dada la situación epidemiológica mundial y el masivo tránsito de viajeros desde y hacia países con circulación viral, existe alto riesgo de importación de casos y desarrollo de brotes si una persona enferma o que esté incubando la enfermedad ingresa al país. Para evitarlo, es fundamental que toda la población esté correctamente vacunada.
En Argentina la enfermedad se encuentra eliminada desde el año 2000 pero para mantener esa situación son necesarias coberturas de vacunación altas. La vacuna es muy segura
El sarampión es una enfermedad viral muy contagiosa que puede tener curso grave o fatal y causar secuelas permanentes. Se propaga fácilmente cuando la persona infectada elimina secreciones respiratorias al hablar, toser o estornudar, o por estar en contacto con cualquier objeto contaminado. Una persona al excretar el virus a través de la saliva puede infectar hasta 14 personas. Los síntomas se caracterizan por fiebre alta, secreción nasal, conjuntivitis, tos, erupción en la cara y cuello que se va extendiendo al resto del cuerpo, y la aparición de pequeñas manchas blancas en la cara interna de la mejilla.
Dada la situación regional que la Secretaría de Gobierno de Salud viene observando, el país cuenta con las vacunas necesarias para proteger a la comunidad y poder así mantener la eliminación de la circulación endémica del sarampión. Además, con el fin de fortalecer la capacidad de los equipos de salud de todas las jurisdicciones para responder de manera rápida, eficiente y oportuna ante casos importados de sarampión, la Secretaría organizó junto con la Organización Panamericana de la Salud, un taller nacional en el que participan referentes provinciales que se está desarrollando en la Ciudad de Buenos Aires desde el martes hasta el viernes.
Por otra parte, el año pasado la Secretaría de Gobierno de Salud realizó una a campaña nacional de seguimiento de sarampión y rubéola a través de la aplicación de una dosis adicional de la vacuna a los niños de 13 meses a 4 años de todo el país. La misma alcanzó una cobertura del 89 por ciento.
En el siguiente vínculo, actualización epidemiológica sobre la confirmación de dos casos de sarampión en turistas extranjeros: https://www.argentina.gob.ar/sites/default/files/sarampion_alerta-11-09-2019.pdf
Vacuna que trata y previene el shock tóxico mortal causado por estreptococos
Una nueva vacuna desarrollada por investigadores del Instituto de Glicómica de la Universidad Griffith, en Australia, tiene el potencial de tratar y prevenir el shock tóxico causado por la enfermedad estreptocócica invasiva, que mata a más de 160.000 personas cada año, según publican en la revista ‘Science Advances’.
“El síndrome de shock tóxico estreptocócico es una afección aguda. Si se expone al organismo, puede morir en cuestión de días. Así que esperamos que lo que descubrimos pueda ayudar a salvar vidas”, explica el líder del programa y el jefe de laboratorio, profesor Michael Good.
La doctora Manisha Pandey, investigadora principal del estudio, explica que el estreptococo (del tipo A) es el mismo grupo de bacterias que causa dolencias comunes y no mortales, como llagas y amigdalitis, que se transmiten fácilmente al toser, estornudar y compartir alimentos y bebidas.
Recuerda que en aproximadamente 1 de cada 100 casos, el microorganismo entra al cuerpo y se convierte en enfermedad estreptocócica invasiva (ISD), que tiene unas tasas de mortalidad superiores al 25 por ciento incluso en las instalaciones mejor equipadas encargadas de tratarlo. Cuando ocurre la ISD, algunas cepas pueden producir más toxinas que otras y causar el síndrome de shock tóxico estreptocócico (STSS).
El STSS ocurre cuando una toxina producida por el organismo Streptococo A se une a una proteína humana en ciertas células y activa las células T en el sistema inmunitario que provocan una citocina o una respuesta altamente inflamatoria.
El equipo de investigación internacional, que incluye científicos de Melbourne y Edmonton, en Canadá, utilizó un modelo de ratón transgénico (genes alterados por ADN) para desarrollar un primer candidato para la vacuna STSS del mundo, llamado ‘J8′, que mostró una reducción de 1000 – 1.000.000 veces carga bacteriana en el bazo y la sangre después de la infección.
Los anticuerpos desarrollados a partir de la proteína estreptocócica M y la exotoxina pirogénica estreptocócica (SpeC) también eliminaron la infección en ratones transgénicos tratados y eliminaron la actividad mitogénica e inflamatoria causada por la proteína M. “Hace unos cuatro años, nos dimos cuenta de un grupo de casos graves de infección estreptocócica que causaron un par de muertes debido a la enfermedad estreptocócica invasiva y el shock tóxico –explica el profesor Good–.
La enfermedad estreptocócica invasiva y el shock tóxico están aumentando en todo el mundo y son particularmente prevalentes entre las poblaciones desfavorecidas. Ocurre en partes remotas del estado entre las comunidades aborígenes, y afecta principalmente a los muy jóvenes y muy mayores”.
Good explica que estaban buscando una vacuna candidata para prevenir las infecciones estreptocócicas. “En ese momento lo estábamos buscando para prevenir la enfermedad cardiaca reumática, que también es causada por el estreptococo A, y pensamos que la vacuna podría prevenir el shock tóxico estreptocócico –recuerda–. Sin embargo, eso no ayuda a las personas que ingresan que no han sido vacunadas y a las personas que están gravemente enfermas con shock tóxico”.
“En nuestro modelo de ratones transgénicos, demostramos que dos proteínas son importantes para la enfermedad: la toxina de superantígeno (SpeC) y la proteína M, de donde proviene nuestro candidato a la vacuna J8 –explica–. Vacunamos a los ratones transgénicos, y podría prevenir el shock tóxico pero, lo que es más importante, pudimos producir anticuerpos en ratones normales que podríamos usar para tratar ratones enfermos”.
Finalmente, “cuando los ratones transgénicos enfermaron mucho, los tratamos con los anticuerpos de la vacuna y se recuperaron durante la noche: los organismos y la toxina se eliminaron de su sangre”, continúa.
El profesor Good dice que ahora que se han generado anticuerpos, el siguiente paso sería producir anticuerpos monoclonales (anticuerpos producidos por células inmunes idénticas que son clones de una célula madre única), que podrían ser adecuados para un estudio de prueba en humanos de la eficacia de J8 contra invasivos enfermedad estreptocócica.
Fuente: Europa Press / COFA
Lo más visto
- Covishield, la vacuna que India lanzó con Oxford-AstraZeneca
- El gobierno establece los requisitos para la producción de cannabis medicinal
- Anmat aprobó en el país la primera vacuna que protege contra el dengue
- Comunicación de Novo Nordisk: Diferencias en la indicación de Victoza® y Saxenda®
- Ibupirac declarado apto para celíacos